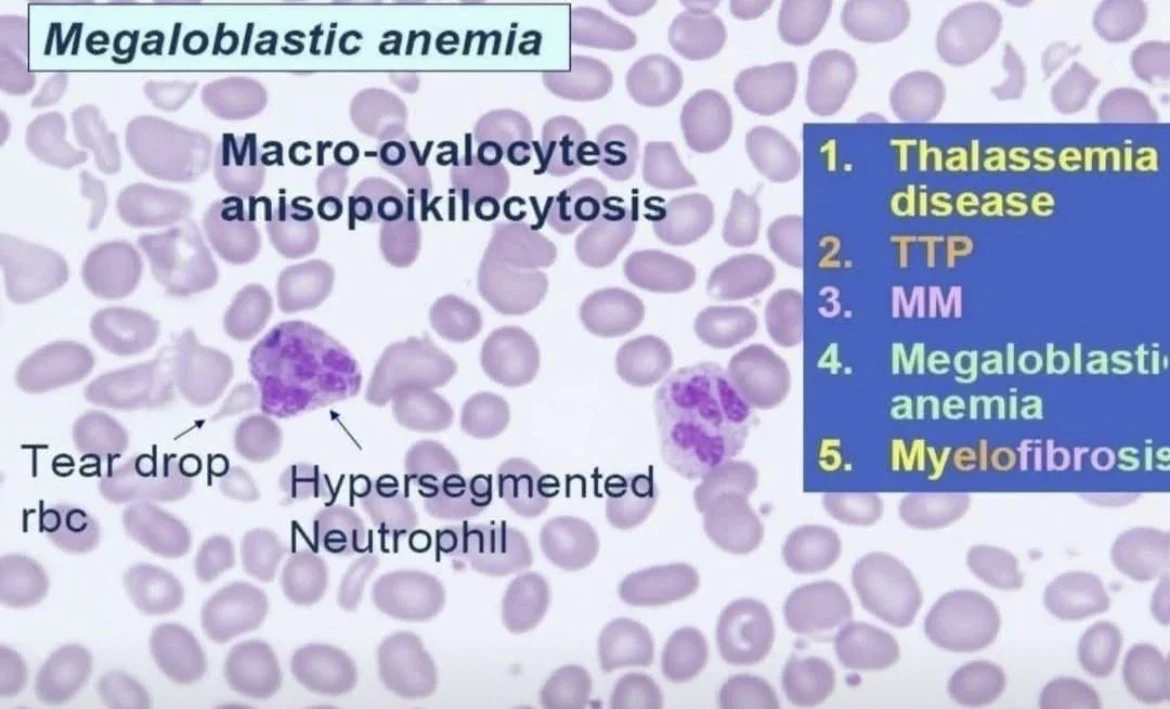
Seema Dawood

Seema Dawood/LinkedIn
Apr 4, 2026, 16:04
Seema Dawood: Clinical and Laboratory Features of Megaloblastic Anemia
Seema Dawood, Medical Laboratory Technologist at The Aga Khan University Hospital, shared a post on Linkedin:
“Megaloblastic Anemia (Folate, Vitamin B12 Deficiency)
Clinical Features
- Vitamin B12 deficiency: Neurological manifestations due to spinal cord involvement, such as difficulty maintaining posture and paresthesia in hands and feet
- Folate deficiency: No neurological symptoms.
Glossitis.
Laboratory Findings
- Blood smear:
RBC: Increased MCV, Macro-Ovalocytes.
WBC: Hypersegmented Neutrophils. - Serum Cobalamin: For detection of Vitamin B12 deficiency.
- Folate level in RBC and serum: For detection of folate deficiency.”
Stay updated with Hemostasis Today.
-
May 23, 2026, 05:38SIUH Advances Precision Stroke Care with Vena MicroAngioscope – Northwell Health
-
May 23, 2026, 05:31Kalyan Roy: Precision Blood Matching in Transfusion-Dependent Thalassaemia
-
May 23, 2026, 05:29Understanding Hepatitis A, B, and C During Hepatitis Awareness Month – UNC Health
-
May 23, 2026, 03:55WFH Initiative Brings Hope to the Hemophilia Community in India
-
May 23, 2026, 03:47Satyam Arora: Welcoming the New ISBT Board for the 2026 Term
-
May 23, 2026, 03:33Brig Tathagata Chatterjee: Connecting With World Leaders in Hematology at ISH Congress
-
May 23, 2026, 03:18Mathangi Kumar: Dental Management Strategies for Congenital Hemophilia
-
May 23, 2026, 03:02Maitri Vaishnav: Anatomical Variability and Surgical Relevance of Corona Mortis
-
May 23, 2026, 02:26Muhammad Hashim: When the Blood Smear Told a Different Story Behind a ‘Critical’ Platelet Count